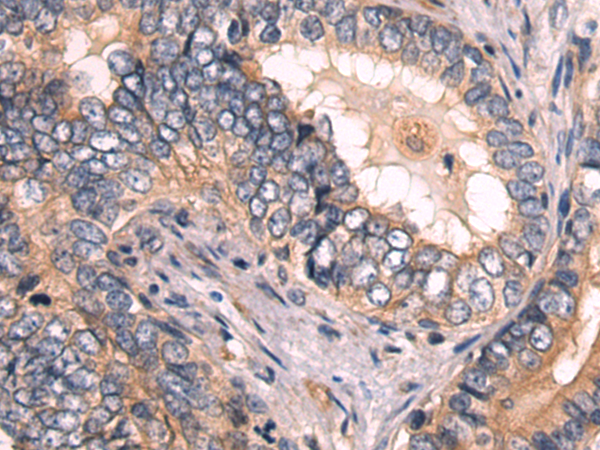
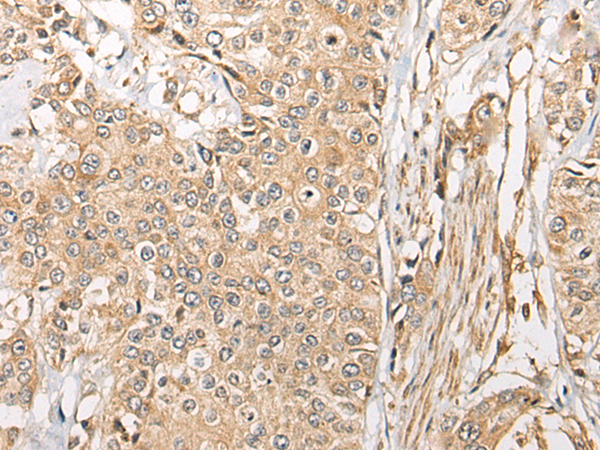
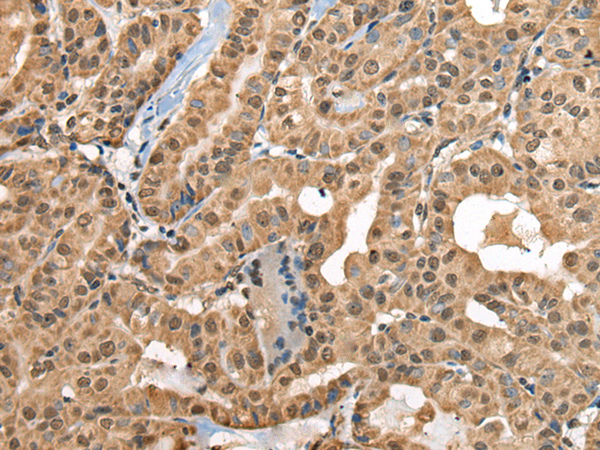

-
分类: 科研抗体货号: P09389别名:应用: WB,IHC反应种属: Human
-
分类: 科研抗体货号: P09414别名: DECRD; MNADK; NADKD1; C5orf33应用: WB,IHC反应种属: Human, Rat
-
分类: 科研抗体货号: P09403别名: DVC1; PRO4323; spartan; C1orf124应用: IHC反应种属: Human, Mouse, Rat
-
分类: 科研抗体货号: P09413别名:应用: IHC反应种属: Human, Mouse, Rat
-
分类: 科研抗体货号: P09402别名:应用: IHC反应种属: Human
-
分类: 科研抗体货号: P09412别名: DKIR; C3IP1应用: IHC反应种属: Human, Mouse, Rat
-
分类: 科研抗体货号: P09432别名: CARPX1应用: IHC反应种属: Human, Mouse
-
分类: 科研抗体货号: P09411别名: TMEM24L; C21orf25; C21orf258应用: WB,IHC反应种属: Human
-
分类: 科研抗体货号: P09431别名: DBQD; DBQD1; SCAN1; SHAPY; SCAN-1应用: WB反应种属: Human, Mouse, Rat
-
分类: 科研抗体货号: P09410别名: FAAP; HSPC117; C22orf28; DJ149A16.6应用: IHC反应种属: Human, Mouse, Rat

鄂公网安备42018502007531号
鄂公网安备42018502007531号

